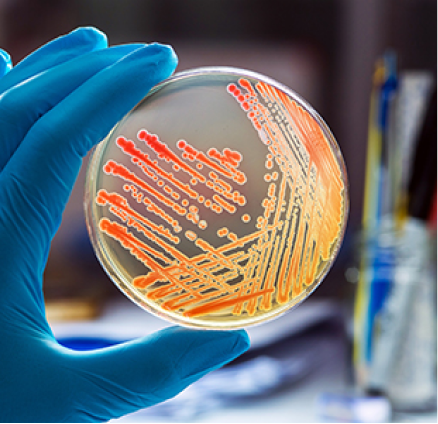
man
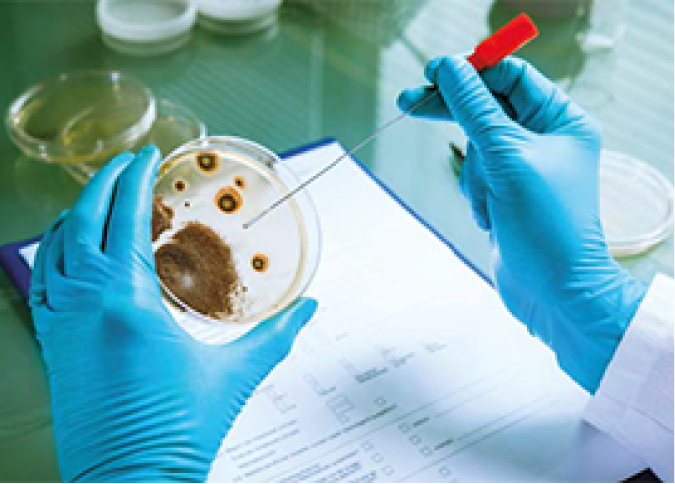
girl

Quality testing Services
Quality testing Services for You Business
At Gigantic Facility Management, we understand the critical role that quality plays in the success of your business. Our Quality Testing Services are tailored to meet the specific needs of your industry and operations, ensuring that your products and services adhere to the highest standards.
Our experienced quality assurance team utilizes advanced testing methodologies and tools to conduct thorough and comprehensive evaluations. From product testing and validation to user experience assessments, we leave no stone unturned in our pursuit of excellence.
With Gigantic Facility Management's Quality Testing Services, you can have the utmost confidence in the reliability and performance of your offerings. Our commitment to delivering accurate and actionable feedback empowers you to make informed decisions and continuously improve your products and services, fostering long-term success and customer loyalty.
Experience the assurance of quality that comes with Gigantic Facility Management's expertise in Quality Testing Services, and elevate your business to new heights of excellence.